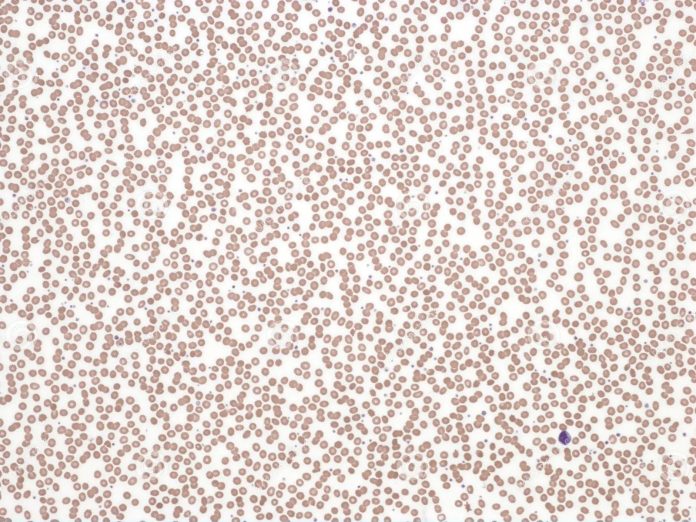

Η ακοκκιοκυτταραιμία οφείλεται, συνήθως, σε κυτταροστατικά φάρμακα ή σε ακτινοβολία ή σπανιότερα είναι αλλεργικής αιτιολογίας.
Ειδικός Παθολόγος-Ογκολόγος, MD, PhD
Όταν ο αριθμός των ουδετερόφιλων λευκοκυττάρων είναι πολύ χαμηλός
Η ακοκκιοκυτταραιμία, ICD-10 D70, είναι μια παθολογική κατάσταση κατά την οποία ο αριθμός των ουδετερόφιλων λευκοκυττάρων είναι κάτω των 100 κυττάρων/mm3, ενώ όταν είναι κάτω των 500/mm3 ονομάζεται ουδετεροπενία.
Οι ακόλουθοι όροι μπορούν να χρησιμοποιηθούν για να καθοριστεί ο τύπος των κοκκιοκυττάρων:
- Ανεπαρκής αριθμός των ουδετερόφιλων: ουδετεροπενία (πιο συνηθισμένη)
- Ανεπαρκής αριθμός των ηωσινόφιλων: ηωσινοπενία (όχι συχνή)
- Ανεπαρκής αριθμός των βασεόφιλων: βασεοπενία (πολύ σπάνια)
Αίτια ακοκκιοκυτταραιμίας
Οφείλεται, συνήθως, (60-80%) σε κυτταροστατικά φάρμακα ή σε ακτινοβολία ή σπανιότερα είναι αλλεργικής αιτιολογίας. Ορισμένα φάρμακα δρουν τοξικώς στο μυελό των οστών (κεντρική δράση) και άλλα δρουν και καταστρέφουν τα λευκοκύτταρα στο περιφερικό αίμα μέσω ανοσολογικού μηχανισμού, κατά τον οποίον το φάρμακο έχει δράση απτίνης (περιφερική δράση).
Τα φάρμακα αυτά είναι, σχεδόν, τα ίδια με εκείνα που κάνουν απλαστική αναιμία. Βέβαια, ισχύει και εδώ, ότι σε κάποια φάρμακα η βλάβη έχει σχέση με τη δόση τους και σε άλλα έχει σχέση με την ιδιοσυγκρασία του ατόμου. Είναι απαραίτητος ο έλεγχος των λευκών, όταν γίνεται λήψη τέτοιων φαρμάκων.
Οι συνηθέστερες ομάδες φαρμάκων που προκαλούν ακοκκιοκυτταραιμία:
• Παράγωγα πυραζολόνης π.χ. μεθιμαζόλη, σκευάσματα χρυσού, p-αμινοσαλικυλικό οξύ, παράγωγα πενικιλίνης, προπανολόλη.
• Παράγωγα φαινοθειαζίνης π.χ. φαινοθειαζίνη, οξυφαινβουταζόνη, φαινυλβουταζόνη, θυρεοστατικά με θείο, σουλφοναμίδες, σουλφονυλουρίες, θειαζιδικά διουρητικά.
Ένας μεγάλος αριθμός φαρμάκων, έχουν συσχετιστεί με ακοκκιοκυτταραιμία, όπως τα αντιεπιληπτικά, τα αντιθυρεοειδικά φάρμακα (καρβιμαζόλη, μεθιμαζόλη και προπυλθειουρακίλη), αντιβιοτικά (πενικιλίνη, χλωραμφενικόλη και κοτριμοξαζόλη), κυτταροτοξικά φάρμακα, χρυσός, Μη Στεροειδή Αντιφλεγμονώδη Φάρμακα (ινδομεθακίνη, ναπροξένη, φαινυλβουταζόνη, μεταμιζόλη), μεβενδαζόλη, το αντικαταθλιπτικό μιρταζαπίνη, και μερικά αντιψυχωσικά (κλοζαπίνη), γι’ αυτό πρέπει συχνά, να ελέγχεται η γενική αίματος.
Αν και η αντίδραση είναι γενικά ιδιοσυγκρασιακή και όχι αναλογική, οι ειδικοί συστήνουν ότι οι ασθενείς που χρησιμοποιούν αυτά τα φάρμακα να παρακολουθούνται για συμπτώματα ακοκκιοκυτταραιμίας που σχετίζονται με λοίμωξη, όπως πονόλαιμο και πυρετό.
Επίσης, η λεβαμιζόλη που είναι ένα αντιελμινθικό, δηλαδή, αντιπαρασιτικό φάρμακο κάνει ακοκκιοκυτταραιμία.

Συμπτώματα ακοκκιοκυτταραιμίας
Κλινική εικόνα: Πυρετός με ρίγος, κακουχία, διόγκωση τραχηλικών λεμφαδένων, νεκρωτικές εξελκώσεις στο στόμα και στο φάρυγγα, επιμένουσα κυνάγχη και σηψαιμία που οδηγεί συχνά στο θάνατο. Η θνητότητα είναι 40%.
Διάγνωση ακοκκιοκυτταραιμίας
Η διάγνωση γίνεται μετά από μια γενική εξέταση αίματος, που είναι μια εξέταση αίματος ρουτίνας. Ο απόλυτος αριθμός ουδετερόφιλων σε αυτό το τεστ θα είναι κάτω από 500, και μπορεί να φτάσει και τα 0 κύτταρα/mm³. Τα άλλα είδη των κυττάρων του αίματος είναι, συνήθως, παρόντα σε κανονικούς αριθμούς.
Για τη διάγνωση, επίσημα, της ακοκκιοκυτταραιμίας, άλλες παθολογικές καταστάσεις με παρόμοια παρουσίαση πρέπει να αποκλείονται, όπως η απλαστική αναιμία, η παροξυσμική νυχτερινή αιμοσφαιρινουρία, η μυελοδυσπλασία, οι λευχαιμίες κ.ά. Αυτό απαιτεί εξέταση του μυελού των οστών, που δείχνει νορμοκυτταρική (φυσιολογικές ποσότητες και είδη των κυττάρων) μυελού των οστών με ανώριμα προμυελοκύτταρα. Τα ανώριμα προμυελοκύτταρα, εφόσον αναπτυχθούν πλήρως είναι τα κοκκιοκύτταρα.
Θεραπεία ακοκκιοκυτταραιμίας
• Διακοπή του ενόχου φαρμάκου.
• Καταπολέμηση λοιμώξεων με τα κατάλληλα αντιβιοτικά.
• Αποχή από υπεύθυνα αλλεργιογόνα.
• Χορήγηση αυξητικών παραγόντων.
• Σε ασθενείς που δεν έχουν συμπτώματα λοίμωξης, γίνεται στενή παρακολούθηση με λήψη αίματος, διακοπή υπεύθυνων φαρμάκων, καθώς και γενικές συμβουλές σχετικά με τη σημασία του πυρετού, αν εμφανιστεί.
• Η λοίμωξη σε ασθενείς με χαμηλά επίπεδα λευκών αιμοσφαιρίων, συνήθως, αντιμετωπίζεται επειγόντως, και συνήθως περιλαμβάνει αντιβιοτικά ευρέως φάσματος με πενικιλίνη (πιπερακιλλίνη-ταζομπακτάμη ή τικαρκιλλίνη-κλαβουλανικό) ή κεφαλοσπορίνη (κεφταζιντίμη) ή μεροπενέμη σε συνδυασμό με γενταμυκίνη ή αμικασίνη.
• Εάν ο ασθενής παραμένει εμπύρετος μετά από 4-5 ημέρες και ο αιτιολογικός οργανισμός για τη μόλυνση δεν έχει ταυτοποιηθεί, προστίθεται βανκομυκίνη, και στη συνέχεια ένας αντιμυκητιασικός παράγοντας (π.χ., αμφοτερικίνη Β).
• Η χρήση ανασυνδυασμένων G-CSF/granulocyte-colony stimulating factor/παράγοντας διέγερσης αποικιών κοκκιοκυττάρων (π.χ. φιλγραστίμη), συχνά, οδηγεί σε αιματολογική ανάκαμψη, αλλά εξαντλείται ο μυελός των οστών.
• Η μετάγγιση κοκκιοκυττάρων θα ήταν μια λύση στο πρόβλημα. Ωστόσο, τα κοκκιοκύτταρα ζουν μόνο ~ 10 ώρες στην κυκλοφορία. Επιπλέον, υπάρχουν πολλές επιπλοκές.
Αν ξεπεραστεί η οξεία φάση, ανάκαμψη της παραγωγής κοκκιοκυττάρων γίνεται σε μία εβδομάδα.
Υψηλής ποιότητας συμπλήρωμα διατρφής για την ακοκκιοκυτταραιμία
Πατήστε, εδώ, για να παραγγείλετε το Υψηλής ποιότητας συμπλήρωμα διατρφής για την ακοκκιοκυτταραιμία

Τα καλύτερα για όσους έχουν ακοκκιοκυτταραιμία
Πατήστε, εδώ, για να παραγγείλετε τα καλύτερα για την ακοκκιοκυτταραιμία

Διαβάστε, επίσης,
Αυξητικοί παράγοντες και καρκίνος μαστού
Η χημειοθεραπεία έχει μεγάλη καρδιοτοξικότητα
Η τοξικότητα των κυτταροστατικών φαρμάκων
Η αντλία νατρίου και καλίου στη θεραπεία του καρκίνου
Τα μονοκλωνικά αντισώματα στη θεραπεία του καρκίνου